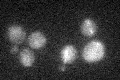
YBR301W

View description
Cell wall mannoprotein with similarity to Tir1p, Tir2p, Tir3p, and Tir4p; member of the seripauperin multigene family encoded mainly in subtelomeric regions; expressed under anaerobic conditions, completely repressed during aerobic growth
Localization:
Intensity:
Fold change:
Significance:
-
C’ GFP library in SD

below threshold14.52 -
N' NOP1pr-GFP in SD

cytosol,nucleus55.002 -
N' TEF2pr-mCherry in SD

below threshold7.47469 -
N' NATIVEpr-GFP in SD

below threshold19.3703 -
N' TEF2pr-VC and Cyto-VN in SD

below threshold24.1707 -
C’ GFP library in SD+DTT

cytosol19.411.33No -
C’ GFP library in SD+H2O2
cytosol16.671.14No -
C’ GFP library in Starvation Media

cytosol16.191.11No -
C’ GFP library on the background of Pup2-DaMP

N/A -
C’ GFP library on the background of CCT mutant

N/A0N/AYes
